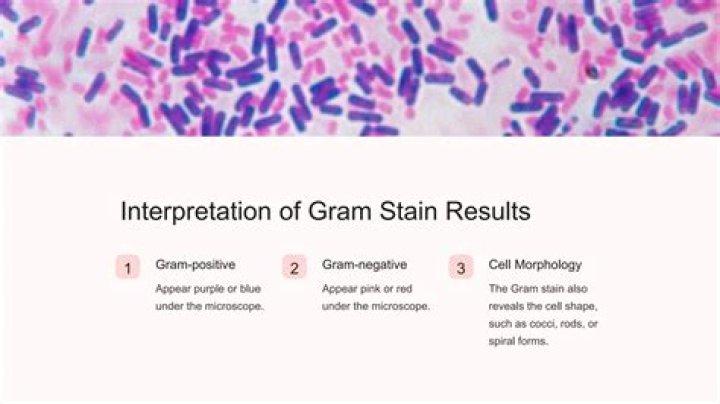

Basil Fanshawe Jagger Father Eva Ensley Mary Scutts Mother
.
In respect to this, does Mick Jagger have brothers and sisters?
Chris Jagger Brother
Also Know, what is Mick Jagger worth? $360 Million
Consequently, what degree does Mick Jagger have?
London School of Economics and Political Science
Who is Mick Jagger's son?
Lucas Maurice Morad Jagger Son Gabriel Jagger Son James Jagger Son Deveraux Octavian Basil Jagger
Related Question AnswersHow old are the Rolling Stones in 2019?
Originally Answered: What ages are the members of the Rolling Stones now? Drummer Charlie Watts is the oldest current member at 78. He turned 78 on June 2nd 2019. Mick Jagger & Keith Richard are 75.What's wrong with Mick Jagger?
The Rolling Stones frontman Sir Mick Jagger has said he is "on the mend" and "feeling much better" after receiving hospital treatment. The singer has reportedly undergone heart valve replacement surgery.How old is Mick Jaggers?
76 years (July 26, 1943)How old is Mick Jagger's youngest daughter?
The Rolling Stones frontman's daughter Georgia May shared a sweet image of her family to Instagram which shows Mick's youngest son, 19-month-old Deveraux Octavian Basil Jagger, crying. The other men in the snap laugh and smile. "Happy Birthday Dada!How old are the stones?
Singer Mick Jagger, 70, lead guitarist Keith Richards, 70, and drummer Charlie Watts, 72, and guitarist Ronnie Wood, the baby of the group at a sprightly 66, are on their 14 on Fire tour, stopping in the capital before moving on to China, Singapore and Australia.Why did Bill Wyman leave the stones?
After playing with the band for more than 30 years, Bill Wyman quit the Rolling Stones in December 1992. The bassist had reached a point where he wanted to make a change due to his frustration with the band. "Playing with the Stones, there was always such a lot of pressure," he told the Telegraph in 2008.When did Jerry Hall get married?
March 4, 2016 (Rupert Murdoch)Who is Jade Jagger's mother?
Bianca JaggerWhich university did Mick Jagger go to?
London School of Economics and Political ScienceWhere has Mick Jagger lived?
Los Angeles DartfordHow many languages does Mick Jagger speak?
EnglishWhat is Mick Jaggers diet?
These days, he eats mainly pasta, chicken, wholegrain bread, potatoes, rice, beans and fish -organic whenever possible. And loads of avocados. He claims that they have regenerative qualities. He says that he eats large portions and puts his slim physique down to his exercise and careful diet.How many babies does Mick Jagger have?
Children. Jagger has eight children with five women. He also has five grandchildren, and became a great-grandfather on 19 May 2014, when Jade's daughter Assisi gave birth to a daughter. On 4 November 1970, Marsha Hunt gave birth to Jagger's first child, Karis Hunt Jagger.How much does Mick Jagger weight?
| Body measurements | |
|---|---|
| Height | 177.8 cm (5 ft 10 in) |
| Weight | 70 kg (154 lb) |
| Shoe size | 12 US |
Did Mick Jagger go to the London School of Economics?
As true fans know, Jagger isn't just the long-tenured front man of the Rolling Stones; he was also a student of finance and accounting at the London School of Economics. He did not graduate from LSE, however; he attended for just a short time.Who was Mick Jagger married to?
Bianca Jagger m. 1971–1978How tall is Mick Jagger Really?
1.78 mHow much is Donald Trump worth?
In its 2018 billionaires ranking, Forbes estimated Trump's net worth at $3.1 billion (766th in the world, 248th in the U.S.). Bloomberg Billionaires Index listed Trump's net worth as $2.48 billion on May 31, 2018, and Wealth-X listed it as at least $3.8 billion on July 16, 2018.Who is the richest rock star?
Top 10 Richest Rock Stars in the World 2020- Keith Richards-Net Worth $340 million.
- Bruce Springsteen-Net Worth $350 million.
- Ringo Starr-Net Worth $350 million.
- Mick Jagger-Net Worth $360 million.
- Elton John-Net Worth-$480 million.
- Jimmy Buffett-Net Worth $550 million.
- Bono-Net Worth $600 million.
- Paul McCartney-Net Worth $1.2 billion.